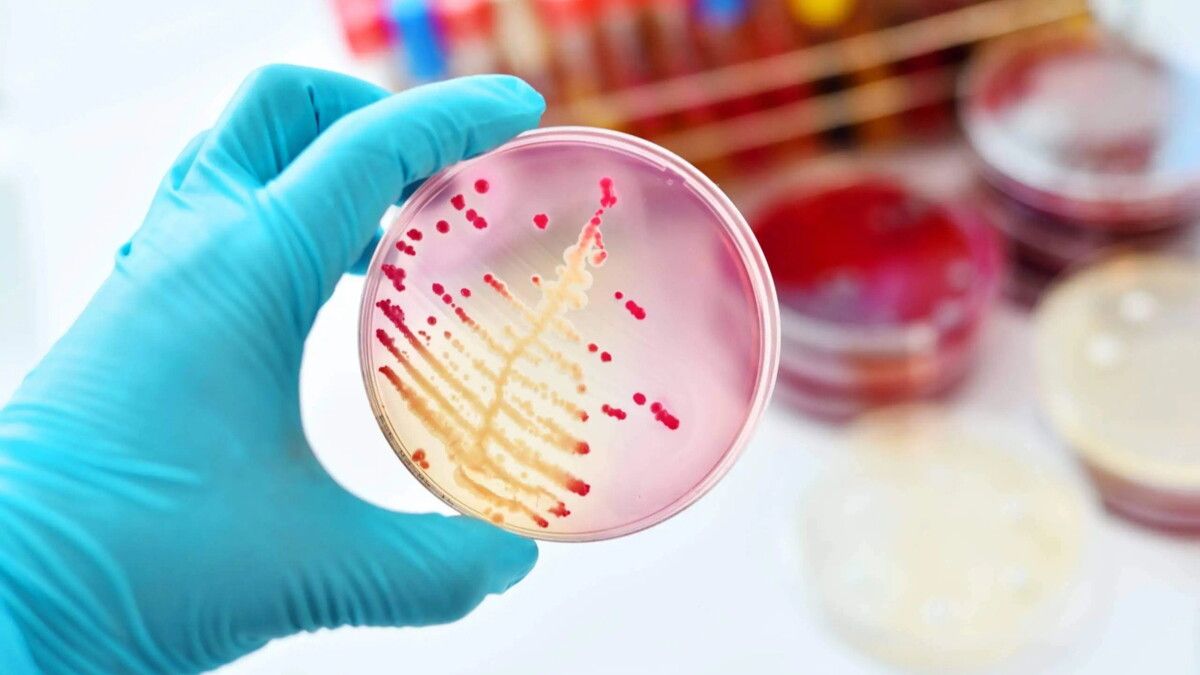
اكتشاف بكتيريا فعالة ضد سلالتين مقاومتين للأدوية

محمد الرخا - دبي - الاثنين 13 يونيو 2022 10:00 مساءً - اكتشف باحثون في الولايات المتحدة، أن البكتيريا التي تتغذى على نفايات البلاستيك الملوث للمحيطات، يمكن أن تنتج مضادات حيوية، تحمي البشر من الجراثيم المقاومة للأدوية.
وذكر الباحثون من جامعة ”ناشيونال“ الأمريكية، أنهم استخدموا ”بلاستيك البولي إيثيلين عالي ومنخفض الكثافة (النوع المستخدم في صناعة الأكياس البلاستيكية)، في المياه قرب رصيف سكريبس في حي لاهويا في ولاية كاليفورنيا الأمريكية لمدة 90 يومًا“، حسبما أفادت صحيفة ”ديلي ميل“ البريطانية.
وأشاروا إلى أنهم ”قاموا بعزل 5 أنواع من البكتيريا المنتجة للمضادات الحيوية من بلاستيك المحيط، بما في ذلك سلالات من ”العصيات“، و“الفايوباكتر“، و“الفيبريو“، ثم اختبروا بعد ذلك البكتيريا المعزولة ضد مجموعة متنوعة من الأهداف الإيجابية والسلبية للجرام“.
”والبكتيريا موجبة الجرام لها جدار خلوي أكثر سمكًا من البكتيريا سالبة الجرام، وغالبًا ما تكون أكثر تقبلاً لبعض المضادات الحيوية التي تستهدف جدار الخلية“، وفق الصحيفة.
ولفتت إلى أن الباحثين وجدوا أن ”البكتيريا المعزولة في اختباراتهم والمنتجة للمضادات الحيوية، فعالة ضد البكتيريا الشائعة إضافة إلى سلالتين مقاومتين للمضادات الحيوية، والتي تعرف باسم الجراثيم الخارقة“.
ونقلت عن أندريا برايس، المؤلفة الرئيسة للدراسة قولها إنه ”بالنظر إلى أزمة المضادات الحيوية الحالية وظهور الجراثيم المقاومة، من الضروري البحث عن مصادر بديلة للمضادات الحيوية الجديدة، ونأمل في توسيع هذا المشروع وزيادة توصيف الميكروبات والمضادات الحيوية التي تنتجها“.
وتشير التقديرات إلى أن ما بين 5 و 13 مليون طن متري من التلوث البلاستيكي يدخل المحيطات كل عام، ويتراوح هذا من الحطام العائم الكبير إلى اللدائن الدقيقة نتيجة تحلل النفايات.
ويمكن للميكروبات أن تستخدم البلاستيك كسطح يمكن أن تتكاثر عليه وتشكل أنظمة بيئية كاملة.
وقال تقرير الـ“ديلي ميل“: ”في حين إنه من المقلق أن البكتيريا المقاومة للمضادات الحيوية قد تتشكل على البلاستيك، فقد تكون بعض الميكروبات قادرة على إنتاج مضادات حيوية جديدة، والتي يمكن استخدامها لمحاربة سلالات البكتيريا المقاومة للمضادات الحيوية في المستقبل“.
وأضاف أن ”البكتيريا المنتجة للمضادات الحيوية تميل إلى التواجد في بيئات طبيعية تنافسية، حيث إنها تخلق المضادات الحيوية لدرء المنافسين على الموارد والمساحة“.
ويسجل اكتشاف النفايات البلاستيكية في جميع أنحاء العالم، ارتفاعا مستمرا، ونتيجة لذلك، يعمل العلماء بجد لإيجاد طرق جديدة لمعالجة المشكلة العالمية للتلوث البلاستيكي، مثل الديدان أو الروبوتات التي تتغذى على البلاستيك وتحوله إلى أدوات مفيدة.
